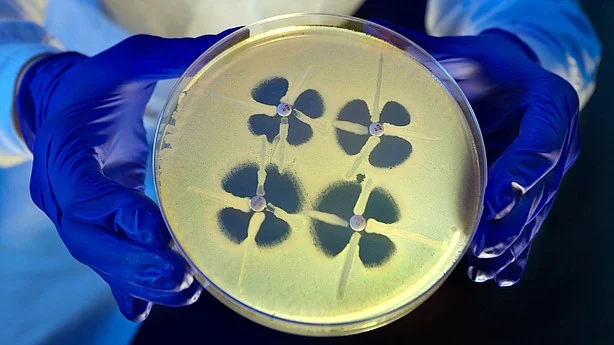
Troubling outbreak of drug-resistant bacteria a growing threat

What You Need to Know About Catheter Infections
/Catheters are commonly used in surgery and other medical procedures. Some people wonder about their safety and if they cause infection. In Urology, we use them all the time. Here's what you need to know.
Read More